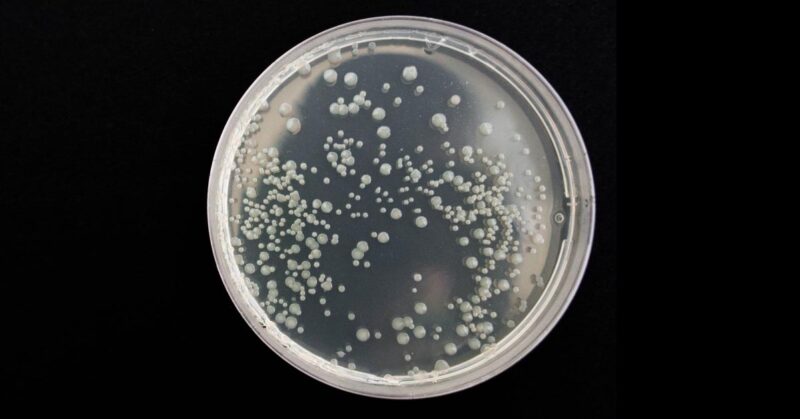
bronchitis Poultry Chicken Bronchitis

Omphalitis or “Mushy Chick”
Omphalitis or “Mushy Chick” is a bacterial infection of a chicks naval due to unsanitary conditions or exposure to other affected chicks. At risk: Newly hatched chicks Symptoms: Bad smell Weak, drowsy appearance Enlarged, blue tinted naval area Cause: Bacteria infection of chick’s naval Unsanitary conditions Exposure to other affected chicks Treatment: Most chicks will…